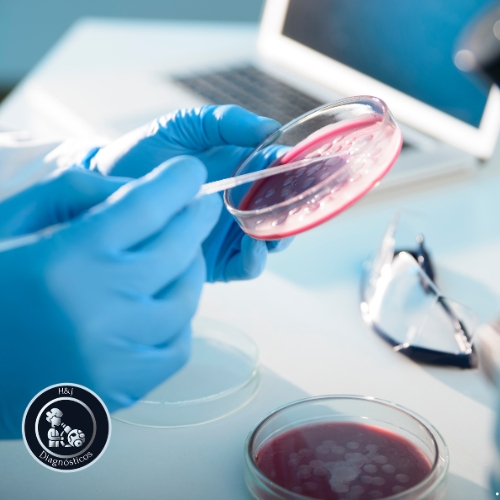

Serviços

Exames de rotina
A realização de exames de sangue é fundamental para avaliar a saúde do paciente e diagnosticar possíveis doenças. Aqui realizamos exames básicos e especializados

Combos de Exames
Buscando atender todos os públicos, desenvolvemos combos de exames para facilitar sua escolha na hora de realizar seu check-up. Aproveite e agende seus exames.

Testes de gravidez
Testes de gravidez são usados para detectar a presença do hormônio hCG no organismo feminino, que é produzido durante a gestação.
Culturas e antibiogramas
Culturas e antibiogramas são ferramentas fundamentais para identificar e selecionar o melhor tratamento para infecções bacterianas. Realizamos exames de Urocultura, cultura de secreções, Coprocultura.

Disponibilizamos mais de 200 tipos de testes de IgE para o diagnóstico de alergias alimentares, poeira, animais.

Análises de urina(EAS)
A análise de urina é um exame laboratorial realizado para avaliar a presença de substâncias e células na urina, auxiliando no diagnóstico e acompanhamento de infecções urinárias e alterações renais
.
Realizamos os principais exames hormonais de tireoide, sexuais, masculinos e femininos. Auxiliando seu médico na melhor conduta no seu acompanhamento.

Testes de intolerância alimentar
Testes de intolerância alimentar são exames que ajudam a identificar quais alimentos podem causar reações adversas no organismo de uma pessoa. Entre eles destacamos o exame de Intolerância a Lactose Genético que diminui a necessidade das furadas para apenas uma coleta é um exame complexo e preciso no diagnóstico da Intolerância

Que tal saber o sexo do seu bebê? Realizamos o teste de Sexagem Fetal um teste genético de rastreio cromossômico com 98% de eficácia e o menor tempo na entrega do seu resultado.
